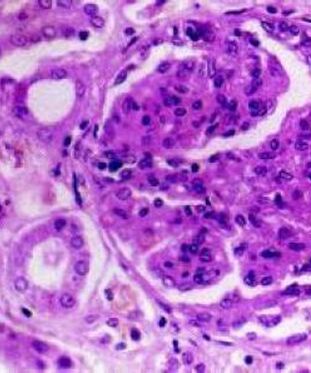
急进性肾小球肾炎,简称急进性肾炎,是肾小球肾炎中最严重的类型

急进性肾炎

急进性肾炎发病急,治疗要点很重要
图片尺寸600x400
老年人急进性肾炎
图片尺寸554x261
急进性肾小球肾炎,简称急进性肾炎,是肾小球肾炎中最严重的类型
图片尺寸311x373
急进性肾小球肾炎,每年必考,较难理解
图片尺寸1024x576
急进性肾小球肾炎
图片尺寸1500x1125
急进性肾炎
图片尺寸1152x720
急进性肾炎的临床表现与诊断
图片尺寸2008x930
急进性肾小球肾炎
图片尺寸920x690
急进性肾炎3型的特点
图片尺寸1152x720
急性和急进性肾小球肾炎对比,你分清了吗?
图片尺寸1640x2360
什么是急进性肾小球肾炎?为什么要强调早诊断,早治疗?
图片尺寸702x548
急进性肾小球肾炎
图片尺寸920x690
《急进性肾小球肾炎》ppt课件_第1页
图片尺寸920x690
急进性肾小球肾炎,简称急进性肾炎,是肾小球肾炎中最严重的类型
图片尺寸378x316
急性和急进性肾小球肾炎对比,你分清了吗?
图片尺寸1640x2360
急进性肾小球肾炎.ppt
图片尺寸920x690
急进性肾炎ppt
图片尺寸1080x810
急进性肾小球肾炎课件_第1页
图片尺寸920x690
急进性肾小球肾炎
图片尺寸1080x810
内科学|急性,急进性肾小球肾炎笔记
图片尺寸1620x2160